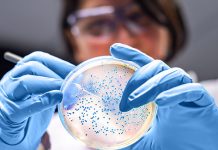
Scientists use AI to detect new family of genes in gut bacteria Scientists use AI to detect new family of genes in gut bacteria

Scientists leave a lasting legacy in climate analysis and prediction
The analysis of global patterns can help scientists develop predictions about the conditions a specific region might experience in the coming weeks, months or...
Study finds deep-sea mining noise pollution will stretch hundreds of miles
New research published today in the peer-reviewed journal Science examines the potential for underwater noise pollution from seabed mining operations, which could affect the...
Scientists see electron whirlpools for the first time
Though they are discrete particles, water molecules flow collectively as liquids, producing streams, waves, whirlpools, and other classic fluid phenomena.
Not so with electricity. While...
Study challenges long-held beliefs about limb regeneration
Ken Muneoka is no stranger to disrupting the field of regeneration; for example, in a 2019 ground-breaking publication in Nature, the Texas A&M University...
New research explores coevolution of mammals and their lice
According to a new study, the first louse to take up residence on a mammalian host likely started out as a parasite of birds....
Scientists use AI to detect new family of genes in gut bacteria
Using artificial intelligence, UT Southwestern researchers have discovered a new family of sensing genes in enteric bacteria that are linked by structure and probably...
Research reveals powerful links between methane and climate change
Scientists from Nanyang Technological University, Singapore (NTU Singapore) have shown that recent record-breaking increases in the atmospheric concentration of greenhouse gas methane can be...
Researchers find greenhouse gas warming likely cause of industrial-era sea level rise
An international team of scientists has developed an accurate record of preindustrial sea level utilizing precisely dated phreatic overgrowths on speleothems that provide a...
Scientists identify the microbes in 100-year-old snail guts
On a drizzly day in July 1920, a Colorado scientist named Junius Henderson was hiking around the Dakota Hogback, a sandstone ridge north of...
New Research shows chemical’s extent in Fairbanks winter air
A chemical compound discovered in 2019 in Fairbanks’ wintertime air accounts for a significant portion of the community’s fine particulate pollution, according to new...
Top News
Hey ISIS, You Suck: Local Muslims Post Anti-ISIS Billboard
A new billboard on Manchester Road in Missouri reads, "HEY ISIS, YOU SUCK!!! From: #ActualMuslims."
A group of Muslim-Americans have put up a blunt billboard...